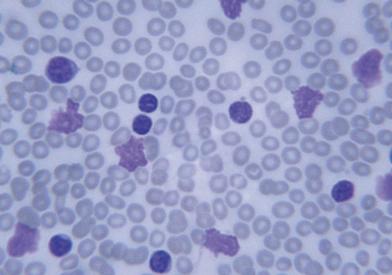

Understanding Your Risk
Certain individuals are at higher risk for these conditions and should consider screening and counseling at the Center. These include:
- Individuals with unexplained blood count abnormalities
- Individuals with a first-degree relative with multiple myeloma or B-cell malignancies are three times more likely to have a precursor blood condition
- Individuals who previously received chemotherapy or radiation for other cancers
Our Services
Patients are cared for by a multidisciplinary team that harnesses Dana-Farber's leadership and expertise in screening, risk assessment, and prevention and interception. This includes hematologist-oncologists who specialize in specific precursor conditions, as well as specialists in genetic risk and prevention, genetic counseling, social support, and more.
Condition-Specific Expertise
Patients meet with a hematologist-oncologist with an in-depth knowledge of their specific precursor condition. The hematologist-oncologist will perform an individualized assessment of the patient’s risk for developing a blood cancer and work with the patient to identify the best management option.
Advanced Diagnostics
Our Center offers advanced diagnostic and sequencing technology to diagnose and assess each patient's condition. When appropriate, patients will have blood and tissue sampling (e.g. bone marrow biopsies). Analysis of these samples help our precursor specialists provide patients with individualized assessments of their risk of progression to blood cancers, discuss therapies and lifestyle changes that impact blood cancer risk, and match interested patients with appropriate therapeutic clinical trials.
Clinical Trial Opportunities
Patients may be offered the chance to participate in clinical research. This may include tissue banking studies such as PCROWD, screening studies such as PROMISE, as well as trials evaluating the effectiveness of novel therapies and lifestyle modifications on preventing progression to blood cancer.
Find Current Clinical Trials
Referral to Specialists
Patients may be referred to other specialists as needed. Examples include:
Cardiology
Patients with CHIP and CCUS are at an increased risk of developing heart disease such as heart attack or stroke. These patients are referred to a cardiologist who specializes in the care of precursor patients for an intensive preventative cardiology evaluation to help reduce the risk of cardiovascular events.
Nephrology
Patients with MGUS may be referred to a nephrologist to evaluate symptoms related to kidney function or to a neurologist if they experience peripheral neuropathy.
Genetic Counseling
Patients may be evaluated by an experienced genetic counselor to discuss their personal and family health history, cancer risk, additional cancer screening recommendations, and potential strategies to lower the risk of progression.
Additionally, patients being actively followed in the Genetics and Prevention Clinic have access to our providers in the Center for Early Detection and Interception of Blood Cancers if they develop a precursor condition.
Social Support
Psychologists and social workers are available by referral to offer patients resources and support.
b35d.jpg?itok=kJRUb9ec)
8d3a.jpg?itok=yPn0ytwv)


0d83.jpg?itok=0aK-4jqO)